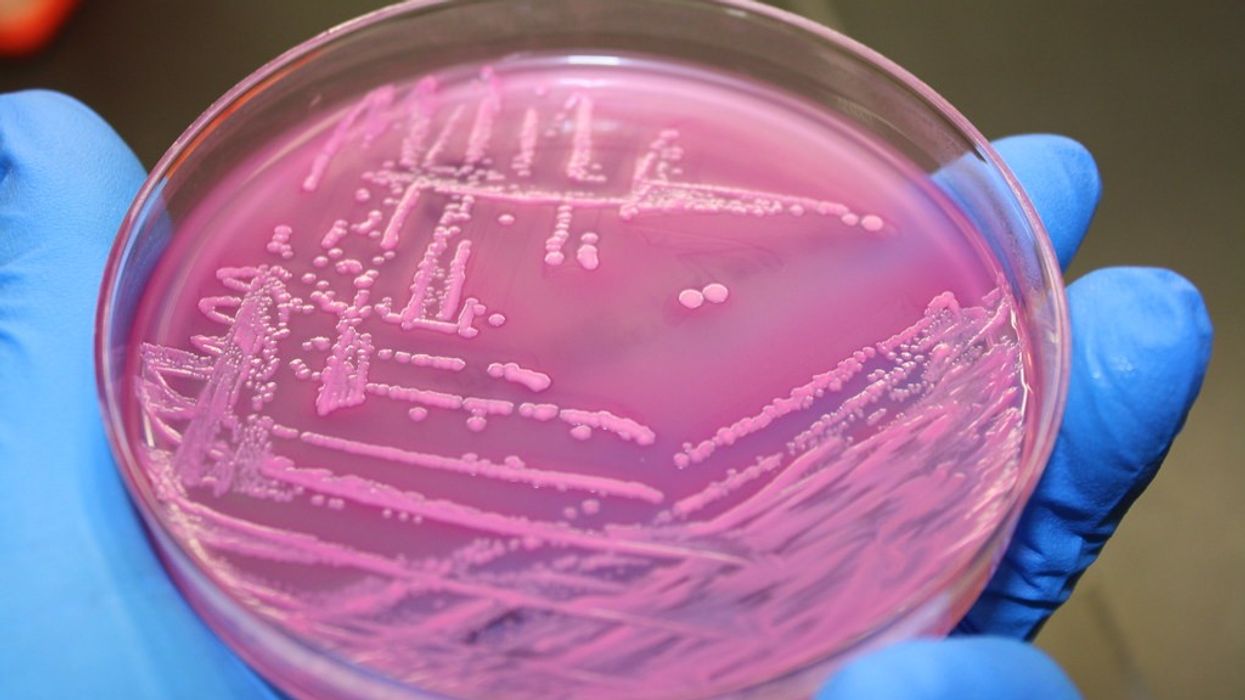
E.Coli in petri dish

One dead and six in hospital after mystery E.coli outbreak in UK
The virus has predominately been affecting children
|Flickr

24 cases of the virus have been reported so far
Don't Miss
Most Read
An E.Coli outbreak in the UK has killed one and hospitalised six others, with health officials left puzzled at the source.
The UK Health Security Agency (UKHSA) is reportedly working with the Food Standards Agency (FSA) to determine what started the outbreak, which is believed to have begun in May.
The UKHSA didn’t provide the ages of the patient who died or who have been hospitalised but said the age range was between “under one to 74”.
The health body have said however that it has predominately been affecting children.

E.Coli can cause Haemolytic Uremic Syndrome (HUS), a life-threatening condition that can lead to kidney failure
|PA
24 cases of the illness have been reported since May, including 19 in England and 4 in Northern Ireland, according to Food Safety News.
Those affected have reported eating grated hard cheese, as well as strawberries, peppers and watermelon, before falling ill.
However, officials have insisted that there is no evidence that any of these foods are responsible.
UKHSA incident director, epidemiologist Amy Douglas said: “The UKHSA has identified an outbreak of a rare form of STEC, with most cases seen in children.
“The outbreak’s source has not yet been identified, but we are working with partners, including the Food Standards Agency, to investigate,” she added.
Symptoms of E.Coli can vary from diarrhoea to vomiting, says UKSHA.
Most people will recover from the illness within five to seven days and do not need to seek medical care.
In more severe cases, the bug can cause Haemolytic Uremic Syndrome (HUS), a life-threatening condition that can lead to kidney failure.
HUS is reportedly what one of the patients affected by the outbreak developed.
The strain circulating currently, is the O183, a very rare strain of E.Coli, with only 15 reported cases in the UK since 2016.
LATEST DEVELOPMENTS

Common symptoms include diarrhoea and vomiting
|Pexels
It can be spread through contact from one infected person to another, as well as through food, water and contact with animals.
Douglas explained that the best way to prevent the disease from spreading is by thoroughly washing your hands with soap and water.
She also said: “Children under five shouldn’t attend school/nursery/group childcare until they have been free of sickness or diarrhoea for two days.
“Visits to hospitals or care home settings should be avoided if you are feeling unwell.”
Officials have ruled out a recent outbreak at a family adventure park in Surrey as the cause of the recent strain spreading.
It has been shut down since July 27 whilst investigations are taking place.









